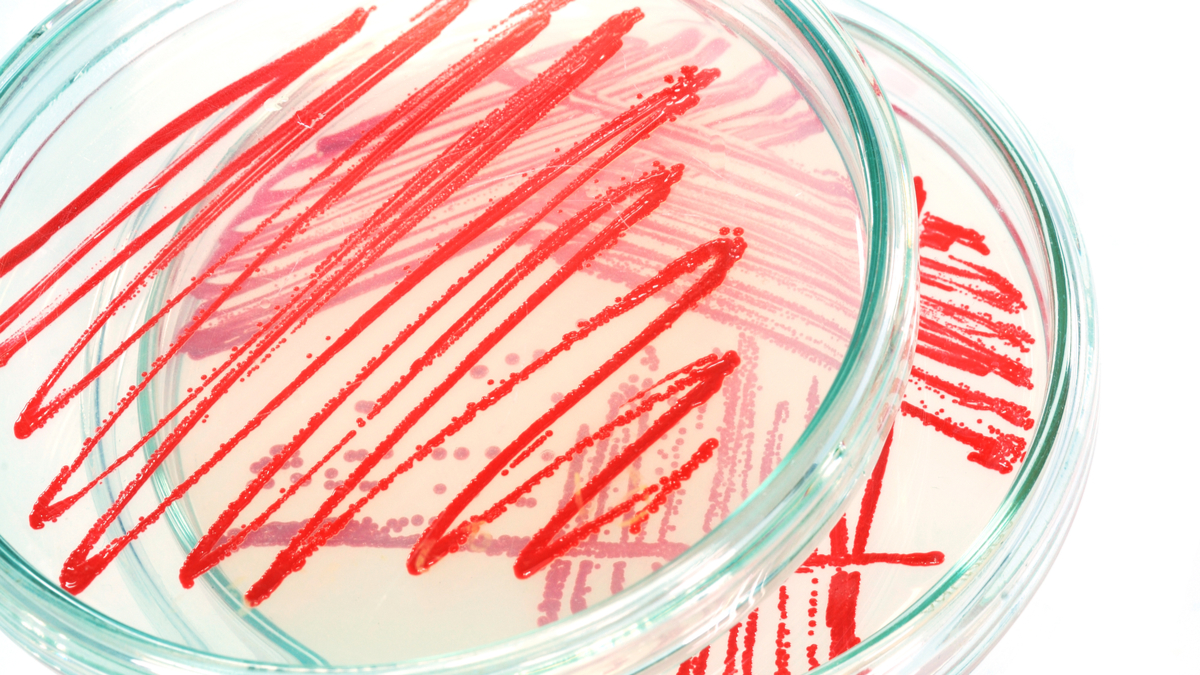

建立實驗文化:除了善用工具,更要翻轉態度
精選專題/ 實驗打造高效率創新
擴大組織實驗規模的能力極為重要,但很多企業難以做到,不是因為技術,而是企業文化。因此,企業必須創造這樣的環境:員工能培養好奇心、資料勝過人的意見、民主領導模式。而高階主管也必須正視每天都可能面對自己想法被證明是錯誤的情況。
(不符合) 小於6段 & 小於700字 (段落: 1/ 字數: 193)
2017年12月,就在假期旅遊旺季即將來臨之前,Booking.com設計總監提出一項激進的實驗:測試公司首頁的全新版面。新的首頁不再提供許多飯店、度假租賃和旅遊方案的選項,而是只有一個小視窗,詢問訪客要去哪裡、日期和團體人數,並提供三個簡單的選項:「住宿」、「航班」和「租車」。Booking.com多年來投注許多心血優化的所有內容和設計元素(圖片、文字、按鈕、訊息),全都將被移除。
(不符合) 小於6段 & 小於700字 (段落: 2/ 字數: 436)Booking.com當時的執行長吉莉安.譚斯(Gillian Tans)對此抱持懷疑態度。她擔心這項改變可能導致忠實顧客感到混淆。當時擔任公司核心實驗團隊負責人的盧卡斯.維米爾(Lukas Vermeer)打賭一瓶香檳,認為這個測試會「沉沒」,也就是說它會拉低公司的關鍵績效指標:顧客轉換率,這是指進行預訂的網站訪客人數。即使瀰漫著這種悲觀態度,為何高階管理階層依舊不駁回測試?因為這樣做會違反Booking.com的核心宗旨之一:公司裡的任何人都可以進行任何測試...
已經是會員?立即登入




